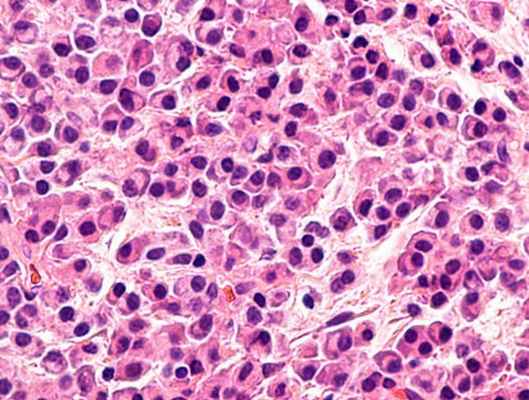
Плазмоцитома (Миеломная болезнь)

Солитарная плазмоцитома - диагностика, лечение
Добавил пользователь Дмитрий К. Обновлено: 02.11.2025
Московский научно-исследовательский онкологический институт им. П.А. Герцена — филиал ФГБУ «Федеральный медицинский исследовательский центр им. П.А. Герцена» Минздрава России, Москва
Московский научно-исследовательский онкологический институт им. П.А. Герцена — филиал ФГБУ «Национальный медицинский исследовательский радиологический центр» Минздрава России, Москва, Россия
Московский научно-исследовательский онкологический институт им. П.А. Герцена, филиал ФГБУ НМИЦ радиологии Минздрава России, Москва, Россия
ФГБУ «Московский научно-исследовательский онкологический институт им. П.А. Герцена — филиал ФБГУ «Национальный медицинский исследовательский радиологический центр» Минздрава России, Москва, Россия
ФГБУ "Московский научно-исследовательский онкологический институт им. П.А. Герцена" Минздравсоцразвития России
Московский научно-исследовательский онкологический институт им. П.А. Герцена — филиал ФГБУ «Федеральный медицинский исследовательский центр им. П.А. Герцена» Минздрава России, Москва
Экстрамедуллярная плазмоцитома желудка
Журнал: Онкология. Журнал им. П.А. Герцена. 2017;6(6): 48‑51
Московский научно-исследовательский онкологический институт им. П.А. Герцена — филиал ФГБУ «Федеральный медицинский исследовательский центр им. П.А. Герцена» Минздрава России, Москва
Представлено клиническое наблюдение солитарной плазмоцитомы желудка. В связи с редкостью этих внекостномозговых опухолей, которые, помимо желудочно-кишечного тракта, могут локализоваться в различных органах и мягких тканях, единой стратегии лечения в настоящее время не разработано. В большинстве случаев в лечении больных с экстрамедуллярной плазмоцитомой желудка используют хирургический метод или радиотерапию, либо комбинацию этих методов. Однако иногда может быть оправдано использование системных противоопухолевых препаратов с целью уменьшения опухолевой массы при нерезектабельности процесса.
Московский научно-исследовательский онкологический институт им. П.А. Герцена — филиал ФГБУ «Федеральный медицинский исследовательский центр им. П.А. Герцена» Минздрава России, Москва
Московский научно-исследовательский онкологический институт им. П.А. Герцена — филиал ФГБУ «Национальный медицинский исследовательский радиологический центр» Минздрава России, Москва, Россия
Московский научно-исследовательский онкологический институт им. П.А. Герцена, филиал ФГБУ НМИЦ радиологии Минздрава России, Москва, Россия
ФГБУ «Московский научно-исследовательский онкологический институт им. П.А. Герцена — филиал ФБГУ «Национальный медицинский исследовательский радиологический центр» Минздрава России, Москва, Россия
ФГБУ "Московский научно-исследовательский онкологический институт им. П.А. Герцена" Минздравсоцразвития России
Московский научно-исследовательский онкологический институт им. П.А. Герцена — филиал ФГБУ «Федеральный медицинский исследовательский центр им. П.А. Герцена» Минздрава России, Москва
Плазмоцитома желудка крайне редкая опухоль желудка. В 1943 г. С. Hellwig, анализируя данные литературы за 37 лет, среди 127 случаев экстрамедуллярных плазмоцитом нашел 5 наблюдений с вовлечением в процесс желудочно-кишечного тракта, и только в 1 случае было поражение желудка [1, 2]. С тех пор в литературе появлялись лишь единичные описания солитарных плазмоцитом с вовлечением желудка. Среди всех плазмоклеточных новообразований желудочно-кишечного тракта частота встречаемости их составляет 3—5% [3—5]. Помимо желудка, в опухолевый процесс наиболее часто вовлекается тонкий кишечник, реже — толстая кишка [6—8].
Мы наблюдали один случай экстрамедуллярной плазмоцитомы желудка.
Приводим клиническое наблюдение.
Больной Г., 44 года, обратился в клинику с жалобами на общую слабость, наличие опухолевого образования в желудке. Из анамнеза известно, что с октября 2015 г. у него появились нарастающая слабость, головокружение, несколько раз наблюдалась мелена. При обследовании по месту жительства диагностирована анемия (гемоглобин 90 г/л), в связи с чем госпитализирован в одну из городских больниц Москвы, где проведено ЭГДС, при которой выявлено образование в желудке. Проведена гемостатическая и противоязвенная терапия с кратковременным улучшением. Пациент был выписан. В дальнейшем его самочувствие стало вновь ухудшаться, за 2 мес отмечено 6 эпизодов желудочного кровотечения, и в тяжелом состоянии больной вновь был госпитализирован. При повторном обследовании выполнена биопсия образования желудка. При гистологическом исследовании высказано предположение о диффузной В-клеточной крупноклеточной лимфоме. Начата противоопухолевая терапия интенсивными курсами по программе R-DA-EPOCH. Выполнено 2 курса без существенного эффекта (рис. 1). Рис. 1. Компьютерная томограмма брюшной полости. Неравномерное утолщение стенки средней трети тела желудка по большой кривизне. Произведена интенсификация лечения с применением программы DHAP в количестве 2 курсов. При обследовании по данным компьютерной томографии (КТ) и впоследствии позитронной эмиссионной томографии (ПЭТ) и КТ в стенке желудка по большой кривизне выявлен участок размером 40×16 мм, с выраженным повышением накопления РФП SUV-6, 12, других очагов патологической метаболической активности не обнаружено (рис. 1, 2). Рис. 2. ПЭТ (а) и КТ (б). Повышенное накопление РФП в стенке средней трети желудка по большой кривизне (SUV-6, 12).

Больной обратился в МНИОИ им. П.А. Герцена. Учитывая неэффективность ранее проведенного лечения, диагноз диффузной В-клеточной крупноклеточной лимфомы подвергся сомнению. С целью верификации опухоли выполнено дообследование. При ЭГДС на границе верхней и средней трети желудка по большой кривизне и передней стенке сохраняется зона опухолевой инфильтрации размером 4×5 см, стенка желудка в этой области каменистой плотности, перистальтика в данной зоне не прослеживается. В центре данной зоны выявлены 2 площадки размером до 1 см, лишенные складок (рис. 3). Рис. 3. Эзофагогастродуоденоскопия. При осмотре в режиме NBI HD слизистая оболочка в данной области лишена архитектоники ямок, визуализируются патологически извитые расширенные капиллярные петли.
При пересмотре гистологических препаратов и проведении иммуногистохимического (ИГХ) исследования биоптата образования желудка в слизистой оболочке определена очагово-выраженная инфильтрация плазматическими и лимфоидными клетками с признаками плазматизации. При ИГХ-исследовании основная масса клеток, инфильтрирующая слизистую оболочку желудка, — CD138, MUM-положительна; реакция в опухолевых клетках с общим цитокератином (AE1/АЕ3), CD20-негативна. Диагноз диффузной В-крупноклеточной лимфомы исключен, диагностирована плазмоцитома желудка.
По данным гистологического исследования костный мозг не поражен. В июне 2016 г. больной госпитализирован в торакоабдоминальное отделение. На основании морфологического варианта опухоли, локального поражения желудка, отсутствия других опухолевых очагов было принято решение о проведении хирургического лечения. Выполнена лапароскопическая парциальная резекция верхней и средней трети тела желудка. При ревизии в брюшной полости диссеминации, выпота, измененных лимфатических узлов не выявлено.
При макроскопическом исследовании в толще стенки желудка определялся плотной консистенции опухолевый узел размером 5,4×4,8×1,5 см, дольчатого строения, с четкими границами. При микроскопическом исследовании опухоль представлена массивным ростом плазматических клеток (рис. 4), Рис. 4. В стенке желудка массивная крупноочаговая инфильтрация плазматическими клетками, занимающая практически всю ее толщу, × 50. признаками лечебного патоморфоза I степени, что проявлялось наличием полиморфных и уродливых многоядерных клеток (рис. 5). Рис. 5. Среди плазматических клеток рассеяны немногочисленные многоядерные уродливые клетки, × 200. Для подтверждения диагноза повторно выполнено ИГХ-исследование. В краях резекции опухолевого роста не выявлено. В опухолевых клетках определялась отрицательная реакция с CD45 и CD20, положительная реакция CD79а, слабая экспрессия CD138, гиперэкспрессия маркера Plasma cell (рис. 6). Рис. 6. При ИГХ-исследовании опухолевые клетки Plasma cell позитивны. Опухолевые клетки лямбда и IgG были позитивны (рис. 7, 8), Рис. 7. При ИГХ исследовании с антителами к легким лямбда-цепям опухолевые клетки позитивны. Рис. 8. Опухолевые клетки экспрессируют IgG. что подтверждало диагноз плазмоцитомы желудка.
В настоящее время больной находится под динамическим наблюдением. Состояние его относительно удовлетворительное. При контрольном обследовании рецидива не выявлено.
Экстрамедуллярная плазмоцитома является редко встречающимся вариантом плазмоклеточных опухолей в отличие от множественной миеломы и солитарной плазмоцитомы костей. Это обусловливает порой трудности в ее диагностике. Морфологический субстрат опухоли составляют зрелые опухолевые плазматические клетки, располагающиеся за пределами костной ткани. При комплексном обследовании не наблюдается поражения костного мозга и костей. В ряде случаев (14—25%) может определяться моноклональная секреция парапротеина в сыворотке крови и белок в моче [9].
Экстрамедуллярные плазмоцитомы в большинстве случаев локализованные образования. Наиболее часто могут поражаться верхние дыхательные пути, околоносовые пазухи, ротоглотка, носовые полости, реже желудочно-кишечный тракт, органы забрюшинного пространства, ЦНС, лимфатические узлы, легкие, кожа [9—12].
Частота поражения желудка среди всех первичных экстрамедуллярных плазмоцитом составляет примерно 2% [13]. Предполагается, что при плазмоцитоме желудка опухолевая трансформация происходит либо в клетках лимфоидных фолликулов подслизистой основы, либо в плазмоцитах собственной пластины (lamina propriа) слизистой оболочки. Макроскопически изменения могут выглядеть как узловая, инфильтративная, язвенная и полиповидная формы [14].
Большинство пациентов с солитарной плазмоцитомой желудка относится к старшей возрастной категории, имеющейся симптомы неспецифического характера (отсутствие аппетита, снижение массы тела, дискомфорт в эпигастрии, эпизоды рвоты и желудочно-кишечные кровотечения) [2, 3, 15].
Пациентам с подозрением на экстрамедуллярную плазмоцитому желудка необходимо проведение комплексного обследования. Первостепенным является выполнение ЭГДС с эндосонографией. Проведение последующего гистологического и иммуногистохимического исследований биоптатов позволяет провести дифференциальную диагностику с другими опухолями желудка: аденокарциномой, стромальной опухолью, иными вариантами лимфом, в первую очередь мукозоассоциированной лимфомой (MALT) с плазмоцитарной дифференцировкой. С целью оценки распространенности процесса проводят расширенное УЗИ, КТ или МРТ грудной и брюшной полостей с контрастом, по возможности ПЭТ/КТ. Для исключения миеломной болезни выполняют морфологическое исследование костного мозга, сцинтиграфию/МРТ костей. ИГХ-исследование сыворотки крови и мочи позволяет оценить секреторную активность опухоли.
В большинстве случаев в лечении больных с экстрамедуллярной плазмоцитомой желудка используют хирургический метод или радиотерапию, либо комбинацию этих методов. С учетом высокой радиочувствительности опухоли, а также при локализации опухоли в области головы и шеи, приоритетным является лучевая терапия [13, 16]. Однако у пациентов с хорошей отграниченностью образований, как в нашем случае, возможно выполнение органосохраняющего оперативного вмешательства.
Прогноз при экстрамедуллярной плазмоцитоме в целом лучше, чем при большинстве лимфопролиферативных заболеваний. Десятилетняя общая выживаемость составляет примерно 70% [9, 13, 17, 18]. Согласно данным литературы, трансформация экстрамедуллярной плазмоцитомы в множественную миелому наблюдается в 16—36% случаев, а при локальных рецидивах — в 22—30% [13, 16]. В этой связи дискутабельным представляется вопрос о применении лекарственной противоопухолевой терапии у больных с первичными экстрамедуллярными плазмоцитомами. В литературе имеются описания клинических случаев эффективного применения таких препаратов, как ингибитор протеасом бортезомиб, иммуномодуляторов талидомид и леналидомид в сочетании с глюкокортикостероидными гормонами и некоторыми цитостатическими препаратами [19, 20]. Принимая во внимание единичность таких наблюдений, а также возможную токсичность системного лечения, вопрос об использовании данного подхода решается в каждом конкретном случае индивидуально. На наш взгляд, его применение в комбинации с лучевой терапией и/или хирургическим вмешательством оправдано при нерезек-табельности больших опухолевых масс с целью сокращения их размеров, наличии нескольких очагов поражения, существенной моноклональной секреции парапротеина, молодом возрасте пациента. При прогрессировании заболевания в множественную миелому необходимо использование лекарственного лечения.
Заключение
Несмотря на хорошие в настоящее время результаты лечения больных с экстрамедуллярными плазмоцитомами, риск развития рецидивов и генерализации опухолевого процесса диктует необходимость проведения длительного динамического контроля за этой группой пациентов, в том числе и с целью выявления поздних осложнений после проведенной противоопухолевой терапии.
Авторы заявляют об отсутствии конфликта интересов.
Сведения об авторах
Плазмоцитома/Миелома

Солитарные плазмоцитомы костей возникают из плазменных клеток, которые располагаются в костном мозге, экстрамедуллярная плазмоцитома — из плазматических клеток на слизистых поверхностях.
Причины развития плазмоцитомы
На протяжении долгих лет ученые ищут причины развития плазмоцитомы. Но, врачи выделяют несколько возможных факторов, что могут способствовать развитию:
— Сильное или длительное радиационное облучение;
— Постоянный контакт с химическими канцерогенами: нефтеперерабатывающие предприятия, лакокрасочные заводы, и другие.
Симптоматика
На начальных стадиях развития плазмоцитомы больной не чувствует особых изменений или симптомов. Заподозрить можно заболевание только при прохождении профилактического осмотра и сдачи анализов.
Позже начинают появляться общие симптомы недомогания, потеря работоспособности, уменьшение веса.
Также симптоматика зависит от вида плазмоцитомы:
* Костная форма сопровождается сильными болями в костях, проблемами с суставами, спонтанные и патологические переломы. Также в результате компрессии корешков спинномозговых нервов и спинного мозга возможны сильные боли по ходу или даже парез конечностей.
* Симптомы экстрамедуллярной плазмоцитомы зависят от локализации опухоли. В случае образования в ЖКТ, появляется тошнота, рвота, расстройства стула, потеря веса, боли в проекции опухоли. Возможны компрессии опухолью сосудов, и как следствие некроза определенной части органа.
Но существуют симптомы, которые характерны для двух форм:
— Дефицит антител приводит к резкому увеличению количества инфекционных заболеваний;
— Возможно повреждение почек, что проявляется изменением биохимических анализов крови и мочи
— Анемический синдром характеризуется постоянной усталостью, головокружением и отсутствие сил.
— Тромбоцитопения приводит к образованию подкожных кровоизлияний и проблемами со системой свертываемости крови.
Диагностика
Провести полную диагностику заболевания вы можете в “КЛИНИКЕ Спиженко”. У нас работают лучшие онкогематологи и проводится исследования согласно современным международным рекомендациям.
На первом приеме врач собирает жалобы и полный анамнез жизни пациента. После этого пациент проходит полную диагностику, которая включает в себя:

— Общий и биохимический анализы крови. Покажет анемию, увеличение скорости оседания эритроцитов, гиперкальциемия. Также оценивается процентное соотношение различных клеток крови, что и дает возможность определить насколько плазмоцитома прогрессирует.
— Анализ мочи на белок Бенс-Джонса.
— Пункция костного мозга. Таким образом, можно оценить степень деление клеток и наличие атипичных клеток.
— Рентгенологические исследование. На снимке будет четко видно отверстие в кости.
— Компьютерная и магнитно резонансная томография . Позволяет определить и оценить степень поражения костного мозга, а также диагностировать экстрамедуллярный вариант плазмоцитомы. Визуализируется инфильтрация или однородно увеличивающуюся масса мягких тканей и лимфаденопатию.
Учитывая то, что большинство пациентов старше 40 лет, у них присутствует достаточно много сопутствующих заболеваний. Поэтому необходимо дополнительно сделать ЕКГ, УЗИ сердца и других органов, сдать коагулограмму и другие анализы. Это нужно для того чтобы, определить фазу заболевания и в случае необходимости провести лечение. Ведь на фоне плазмоцитому, часто могут просыпаться хронические заболевания.
Для предотвращения или превентивных действий можно провести цитогенетическое исследование, что покажет предрасположенность к образованию плазмоцитом и таким образом обозначить группу риска.
Лечение плазмоцитомы
После полной диагностики, установления стадии, формы онкогематолог приступает к лечению. Главная задача в лечение плазмоцитомы это остановить рост и прогрессирование, перевести ее в ремиссию и сделать все чтобы не было рецидивов.
Для этого врач может использовать три направления терапии:
В большинстве случаев заболевания, врачи комбинируют хирургический метод лечения с химиотерапией или облучением, для того чтобы, увеличить шансы на излечение.
Таким образом врач достигает остановки роста патологических клеток и проводит их удаления.
Также параллельно проводится поддерживающая терапия, которая направлена на решения проблем в других системах органов, что создала опухоль:
— Анемию. Назначают рекомбинантный человеческий эритропоэтин, иногда прибегают к инфузии препаратов крови для быстрого восстановления количества эритроцитов.
— Инфекции. Назначают антибиотики, такие как фторхинолоны или цефолоспорины. Также используют противовирусные и противогрибковые препараты.
— Сгущения крови. Назначают профилактическую противотромботическую терапию антикоагулянтами.
Все лечения строго проводится под контролем онкогематолога, а также сопутствующих врачей(кардиологов, неврологов, сосудистых хирургов,нефрологов), которые контролируют течения и активность хронических заболеваний.
Плазмоцитома
Плазмоцитома: причины появления, симптомы, диагностика и способы лечения.
Определение
Плазмоцитома – это злокачественная В-клеточная опухоль. Ее субстратом является плазматическая клетка (плазмоцит). Плазмоциты образуются из лимфоцитов группы В, их основная функция – производство защитных белковых соединений – иммуноглобулинов, в ответ на внедрение в организм патогенных микроорганизмов.
При плазмоцитоме в результате хромосомных нарушений возникают патологические В-клетки, которые дифференцируются до плазмоцитов, а те в свою очередь начинают продуцировать иммуноглобулин одного класса (моноклональный иммуноглобулин) в избыточном количестве. Структура иммуноглобулина при этом не нарушена, но синтез его или его отдельных компонентов значительно превышает физиологическую потребность организма. Дефектный иммуноглобулин не может выполнять свою защитную функцию, при этом выработка нормальных защитных антител снижается.
Плазматические клетки скапливаются в костном мозге и поражают кости скелета и ткани внутренних органов, ассоциированных с лимфоидной тканью.
Со временем патологические плазмоциты в костном мозге вытесняют нормальные кроветворные клетки, снижается количество лейкоцитов, тромбоцитов, эритроцитов.
Причины возникновения плазмоцитомы
Причины развития плазмоцитомы в настоящий момент окончательно не установлены. Предполагается роль генетических нарушений, которые могут возникать под воздействием провоцирующих факторов (хронических вирусных инфекций, пребывания в зоне радиоактивного облучения, длительного воздействия токсических веществ, приема препаратов, угнетающих иммунитет).
При внутрикостном развитии опухолевого процесса разрушается кортикальный слой кости и плазмоцитома выходит за пределы костной пластинки, прорастая в окружающие ткани или спинномозговой канал. При гематогенном пути распространения плазматических клеток формируется изолированная экстрамедуллярная плазмоцитома в органах и тканях, никак анатомически не связанных с костью.
Причиной экстрамедуллярного распространения опухолевых клеток могут оказаться инвазивные процедуры и хирургические вмешательства (например, лапаротомия).
Классификация заболевания
Плазмоцитома может иметь один патологический очаг или генерализованное течение (в патологический процесс вовлечены разные органы и системы организма, что наблюдается у пациентов старшей возрастной группы).
Плазмоцитомы подразделяются на солитарную плазмоцитому (затронуты, как правило, кости скелета (ребра, позвоночник, череп, кости таза)) и экстрамедуллярную плазмоцитому (патологический процесс может быть обнаружен в любых органах и тканях, но самая частая локализация – горло, печень, кожа, лимфоузлы, легкие, плевра, почки, поджелудочная железа).
Кроме того, выделяют солитарную плазмоцитому без присутствия клональных плазматических клеток в костном мозге, и солитарную плазмоцитому с низким уровнем вовлечения костного мозга.
Кроме того, плазмоцитома может быть одним из проявлений множественной миеломы.
Симптомы плазмоцитомы
Симптомокомплекс заболевания зависит от локализации очага и степени распространенности патологического процесса.
О повреждениях костной ткани свидетельствуют такие симптомы, как боли в костях (более чем у 70% пациентов в дебюте заболевания), переломы костей скелета, компрессия спинного мозга, радикулярные (корешковые) боли. Наиболее часто боль локализуется в спине и ребрах, реже – в конечностях.
Для солитарной плазмоцитомы костей характерно повышение уровня кальция в крови, что сопровождается тошнотой, рвотой, слабостью, запорами, повышенной жаждой.
Некоторые пациенты не испытывают никаких симптомов, и опухолевые процесс выявляется случайно – при проведении диагностических мероприятий по иным заболеваниям.
Наиболее частыми симптомами экстрамедуллярной плазмоцитомы с поражением верхних отделов дыхательных путей являются заложенность носа, носовые кровотечения, осиплость голоса, снижение/потеря слуха. Экстрамедуллярная плазмоцитома кишечника характеризуется присутствием абдоминальной боли (боли в животе), непроходимостью кишечника, тошнотой, рвотой, вздутием живота и запорами. Может присутствовать синдром мальабсорбции (нарушения всасывания в кишечнике), вызывающий потерю веса. Для экстрамедуллярной плазмоцитомы желудка характерно желудочное кровотечение.
Генерализованная плазмацитома (множественная миелома) может сопровождаться не только поражением костной ткани, но и почек, когда в почечных канальцах откладывается патологический белок в виде цилиндров – цилиндровая нефропатия. Почечная недостаточность проявляется тошнотой, рвотой, недомоганием и слабостью. Накопление аномальных клеток в костном мозге нарушает нормальное кроветворение, что приводит к анемии (из-за подавления роста эритроцитов), геморрагическому синдрому (кровоизлияниям) из-за нехватки тромбоцитов.

Диагностика плазмоцитомы
Постановка диагноза «солитарная плазмоцитома» требует очень тщательной оценки для исключения генерализации процесса (множественной миеломы).
Из лабораторных обследований при подозрении на плазмоцитому назначают:
- общий (клинический) анализ крови;
Синонимы: Общий анализ крови, ОАК. Full blood count, FBC, Complete blood count (CBC) with differential white blood cell count (CBC with diff), Hemogram. Краткое описание исследования Клинический анализ крови: общий.
Плазмоцитома
Плазмоцитома – это злокачественная опухоль из плазматических клеток, которая поражает кости и внутренние органы. Заболевание может протекать в солитарной форме при наличии только одного патологического очага либо в генерализованном варианте, когда в процесс вовлекаются разные системы организма. Плазмоцитома отличается многообразием и неспецифичностью клинической симптоматики, которая зависит от вида и локализации опухоли. Диагностика заболевания включает рентгенографию и КТ, исследование биоптатов костного мозга, клинический и биохимический анализы крови. Для лечения используется лучевая терапия, полихимиотерапия, комплексная реабилитация.
МКБ-10



Общие сведения
В клинической онкогематологии плазмоцитома относится к парапротеинемическим лейкозам. Она встречается с частотой около 3 случаев на 100 тыс. населения, однако распространенность болезни резко увеличивается с возрастом ‒ до 37 случаев на 100 тыс. пожилых людей. Средний возраст пациентов при диагностике опухоли составляет 55-74 года. Среди всех больных мужчины составляют 61%. Более подвержены заболеванию лица негроидной расы. Среди опухолевых процессов кроветворной системы на долю всех типов плазмоцитомы приходится 10-14%.
Причины плазмоцитомы
Этиологическая структура плазмоклеточных опухолей точно не установлена. Важная роль в развитии заболевания отводится продолжительной антигенной стимуляции иммунных клеток на фоне хронических инфекций, аутоиммунных заболеваний, воздействия экзогенных токсинов и радиации. Доказана генетическая предрасположенность к возникновению парапротеинемических опухолей. Риск развития болезни повышается у людей с хромосомными аберрациями.
Основным немодифицируемым фактором риска плазмоцитомы признан возраст. Единичные (солитарные) опухоли более характерны для пациентов предпенсионного возраста 55-60 лет, около 30% случаев болезни развиваются среди людей младше 50 лет. Генерализованная форма болезни имеет возрастную медиану около 70 лет, только у 35% людей она выявляется до 65-летнего возраста. К модифицируемым предрасполагающим факторам относят профессиональные вредности, проживание в регионах с неблагоприятной экологической ситуацией.
Патогенез
Парапротеинемические гемобластозы, к которым относится плазмоцитома, представляют собой опухоли из единого клона В-лимфоцитов. Под действием провоцирующих факторов происходит злокачественная трансформация первичной клетки, из которой образуется линия с аналогичными мутациями и способностью к неограниченному делению. Новообразование секретирует определенный вид иммуноглобулинов, наличие которых является основой для постановки диагноза.
Патоморфологически мутантные В-лимфоциты характеризуются выраженным полиморфизмом и атипией, наличием клеточных ядер аномальной формы, крупными ядрышками. Характерным признаком считается «пламенеющая» цитоплазма с множественными включениями. Цитологические отличия плазматических клеток более выражены при малодифференцированных вариантах опухоли.

Классификация
Существует несколько вариантов систематизации новообразований. По степени зрелости мутантных клеток бывают высоко- и низкодифференцированные плазмоцитомы. По иммуногистохимическим особенностям выделяют А-миелому, D-миелому, G-миелому. Наиболее важна классификация по клинико-морфологическим признакам, согласно которой выделяют две разновидности плазмоцитомы:
- Солитарная. Составляет до 5% всех опухолевых образований, характеризуется наличием локальной пролиферации клональных плазматических клеток. Признана прогностически благоприятным вариантом заболевания.
- Генерализованная (множественная миелома). Характеризуется неконтролируемой пролиферацией В-лимфоцитов в разных органах и тканях тела, развивается на фоне хромосомных нарушений и патологии стромального окружения. Распространенная форма, которая составляет до 1% среди всех злокачественных новообразований.
Единичные парапротеинемические опухоли дополнительно делятся на две подгруппы: солитарная плазмоцитома кости (СПК) и экстрамедуллярная плазмоцитома (ЭМП). СПК встречается в 2-5 раз чаще, чем ЭМП. В основном поражаются кости позвоночника (42-61%), таза (15%), ребер (12%). Среди экстрамедуллярных новообразований до 85% расположено в зоне головы и шеи, также возможно вовлечение в процесс легких, органов ЖКТ, урогенитального тракта.
Симптомы плазмоцитомы
Клинические проявления солитарного новообразования определяются расположением опухолевого очага. При поражении костной ткани на первый план выходит локализованный болевой синдром, который беспокоит пациента постоянно, не имеет четкой связи с физической нагрузкой или сменой положения тела. При сдавлении близлежащих нервных структур развиваются нейропатии и радикулопатии, для которых характерны стреляющие боли, нарушения чувствительности.
Ведущими симптомами при ЭМП считаются признаки поражения ЛОР-органов, что связано с типичной локализацией опухоли. Пациенты жалуются на заложенность носа, которая не купируется сосудосуживающими каплями, периодические носовые кровотечения, образование сухих корок в назальной полости. Реже встречается осиплость голоса, затруднения глотания, снижение слуха и боль в ухе.
ЭМП в нижних дыхательных путях манифестирует эпизодами одышки на фоне бронхообструкции, длительным кашлем, тяжестью и болями в грудной клетке. При расположении экстрамедуллярной плазмоцитомы в брюшной полости возникают неспецифические боли в животе, хронические запоры, тошнота и рвота. Парапротеинемическая опухоль урогенитального тракта проявляется расстройствами мочеиспускания, появлением крови в моче, болями в области поясницы.
Множественная миелома в 10-20% случаев протекает бессимптомно, манифестные варианты заболевания характеризуются разнообразными сочетаниями вышеописанных признаков. Чаще всего появляются боли в позвоночнике, грудине и ребрах, которые сопровождаются патологическими переломами и остеопорозом. Пациентов беспокоят диспепсические и дизурические расстройства, мелкие кровоизлияния в кожу, желудочные, носовые и легочные кровотечения.
Осложнения
У 60% больных с множественной миеломой обнаруживается средняя или тяжелая степень анемии, которая сопровождается гемической гипоксией. В 50-90% случаев присоединяется почечная патология, которая является одной из основных причин сокращения продолжительности жизни пациентов. На фоне приобретенной иммунной недостаточности развиваются рецидивирующие и генерализованные инфекции органов дыхания, мочевыводящих путей.
При плазмоцитоме наблюдается гиперпродукция моноклональных иммуноглобулинов, которая вызывает амилоидоз внутренних органов. Экстрамедуллярная опухоль может стать причиной механической желтухи, перфорации кишечника, межпетлевой фистулы. При появлении опухолевых масс в области шеи происходит компрессия дыхательных путей, которая в ряде случаев вызывает асфиксию и требует неотложной медицинской помощи.
Диагностика
Обследование пациента проводится врачом-онкогематологом. Диагностические мероприятия начинаются со сбора жалоб, выяснения условий появления симптоматики, физикального осмотра с пальпацией болезненных участков тела. Выявление парапротеинозов требует всестороннего обследования здоровья, которое включает следующие лабораторно-инструментальные методы:
- Рентгенодиагностика. При костных болях назначается рентгенография грудной клетки, позвоночника и конечностей, с помощью которой определяются объемные новообразования. Для точной визуализации опухолей и определения степени распространенности процесса проводится КТ пораженной области тела. Методика ПЭТ-КТ показана для диагностики генерализованной плазмоцитомы.
- Биопсия костного мозга. При солитарной форме обнаруживается нормальная цитологическая картина. При множественной миеломе в результатах исследования выявляется более 10% плазматических опухолевых клеток. При солитарных новообразованиях целесообразно проведение биопсии опухолевой ткани для гистологической диагностики.
- Анализы крови. При плазмоцитоме обнаруживается снижение уровня гемоглобина менее 100 г/л, повышение СОЭ, слипание эритроцитов в виде «монетных столбиков». Реже встречается лейкопения и тромбоцитопения. У 20-40% больных определяется гиперкальциемия.
- Иммунологическая диагностика. Патогномоничным признаком болезни является сывороточный моноклональный М-белок (парапротеин). Для уточнения диагноза проводится определения типа и класса иммуноглобулинов в сыворотке крови и образцах мочи. Для выяснения степени зрелости плазмоцитомы назначаются иммуногистохимические исследования опухолевых биоптатов.

Дифференциальная диагностика
При постановке диагноза «солитарная плазмоцитома» необходимо проводить тщательную оценку инструментальных данных, поскольку нередко при дифференциальной диагностике выявляется множественная миелома. В процессе обследования нужно исключить:
- саркому Юинга;
- моноклональные доброкачественные гаммапатии;
- макроглобулинемию Вальденстрема;
- гиперпаратиреоз;
- остеохондроз;
- хронический гломерулонефрит.
Лечение плазмоцитомы
Консервативная терапия
Злокачественные плазмоцитарные клетки имеют высокую чувствительность к радиации, поэтому при солитарных новообразованиях методом выбора является локальная лучевая терапия. Она способствует стабилизации или регрессу плазмоцитомы у 80% пациентов. Рентгенологическими маркерами эффективности лечения считаются склероз и реминерализация пораженной костной ткани. Курсовая лучевая терапия проводится всем пациентам с множественной миеломой.
Эффективным направлением лечения плазмоцитомы является полихимиотерапия, которая показывает наилучшие результаты у пациентов младше 65 лет без тяжелых сопутствующих заболеваний. Лечение направлено на максимально возможную редукцию клона опухолевых клеток. Для химиотерапии плазмоцитарной опухоли могут назначаться 5 классов лекарственных средств:
- алкилирующие агенты;
- глюкокортикостероиды;
- ингибиторы протеосомы;
- иммуномодулирующие препараты;
- антрациклины.
Хирургическое лечение
Оперативное вмешательство рассматривается как метод выбора при солитарной плазмоцитоме, которая находится в доступном для удаления месте. Иссечение основного объема опухолевых клеток улучшает функцию пораженного органа или кости, повышает эффективность радиотерапии. При патологических переломах требуется помощь травматолога-ортопеда для репозиции костных отломков, проведения оптимального метода остеосинтеза.
Паллиативная помощь
Несмотря на усовершенствование методов лечения, средняя выживаемость при генерализованной плазмоцитоме составляет около 3 лет. Пациентам в терминальной стадии заболевания показано паллиативное лечение, которое включает адекватные дозы наркотических анальгетиков и других обезболивающих препаратов, профилактику и лечение инфекционных осложнений, дистантную лучевую терапию. Больным необходим уход в рамках специализированных стационаров.
Реабилитация
Всем пациентам с плазмоцитомой требуется диспансерное наблюдение у онкогематолога на протяжении жизни. Для улучшения качества жизни подбирается программа комплексной реабилитации, которая включает симптоматическое лечение, контроль свертывающей способности крови, применение ортезов для улучшения функции опорно-двигательного аппарата. Большое внимание уделяется психосоциальной реабилитации.
Прогноз и профилактика
Результативность лечения и ожидаемая продолжительность жизни зависит от формы и степени тяжести парапротеиноза. Генерализованная плазмоцитома считается прогностически неблагоприятным заболеванием, особенно в сочетании с выраженной миелодепрессией, быстрым ростом опухолей, стремительным нарастанием уровня сывороточного парапротеина. Учитывая неясную этиологию, эффективные меры профилактики не разработаны.
1. Солитарная (экстрамедуллярная) плазмоцитома. Клинические рекомендации/ Н.А. Фалалеева, А.Ю. Терехова, В.В. Птушкин, Е.А. Османов// Клиническая онкология. – 2020. – №1.
2. Цитологические особенности плазмоцитомы и дифференциальные признаки опухоли Юинга, неходжкинских лимфом и железистого рака/ Л.С. Болгова, О.И. Алексеенко, Т.Н. Туганова, Т.М. Ярощук// Клиническая онкология. – 2019. – №1.
Плазмоцитома (Миеломная болезнь)
Плазмоцитома - это злокачественное поражение кровеносной системы. В результате сбоя начинается бесконтрольная и чрезмерная выработка клеток плазмы. Моноклональные антитела, «иммуноглобулины», нарушают кроветворные функции. На смену здоровым клеткам в костном мозге появляются больные
Миеломная болезнь, или плазмоцитома – диагноз относительно не распространенный, но оттого – не менее опасный. Каждый год его слышит, как минимум, четыре человека на сотню тысяч населения. В группе риска – люди старшего поколения, но все чаще плазмоцитому выявляют и у довольно молодых людей в возрасте от 25 лет. Средний возраст заболевших – 40-45 лет, чаще диагноз «миеломная болезнь» ставят мужчинам.
В чем опасность этого заболевания? Шаг за шагом, миелома поражает не только костную и кровеносную, но и значительно снижает иммунитет, затрагивает почечную и другие жизненно важные системы организма.
Симптомы заболевания
Ранняя диагностика плазмоцитомы – это возможность продлить жизнь пациента и ощутимо улучшить ее качество. Важно вовремя услышать первые «звоночки», сигналы, которые посылает организм.
В числе распространенных симптомов миеломной болезни:
- Боли костей – преимущественно, они локализуются в тазовой области, позвоночнике, плечах, ребрах;
- Частые переломы костей, компрессионные переломы позвоночника;
- В отдельных случаях за ними заметное уменьшение роста;
- Потеря чувствительности в конечностях, и особенно – в пальцах ног и рук, частое онемение и болевой синдром;
- Регулярные отеки и болевые ощущения в области почек;
- Проблемы с мочеиспусканием, вплоть до полного отсутствия мочи;
- Частые головокружения, слабость, нарушения координации, быстрое снижение веса;
- Точечные кровотечения на коже;
- Постоянное повышение температуры — до 39 градусов.
Очевидно, что заболевание дает о себе знать серьезной симптоматикой, которую невозможно проигнорировать. Качество жизни с наступлением плазмоцитомы очень быстро и значительно снижается.
Основные формы развития заболевания
Самая распространенная форма плазмоцитомы – солитарная. В этом случае мутация клеток плазмы происходит локально: возникает солитарная (то есть, одиночная) опухоль. Такая плазмоцитома чаще всего поражает костную ткань позвоночника, черепа и грудной клетки. Иногда ее диагностируют и в трубчатых длинных костях. При быстром и сильном росте опухоли костная ткань начинает разрушаться. В этом случае есть риск, что миеломная болезнь поразит и другие системы организма, перейдет на внутренние органы.
Экстрамедуллярная плазмоцитома не получила такое значительное распространение, как солитарная. Эту форму злокачественной опухоли диагностируют лишь у 20% пациентов, чей диагноз был подтвержден. О такой форме говорят в случае, если миелома поразила не костные, а мягкие ткани. Чаще всего экстрамедуллярная плазмоцитома затрагивает желудочно-кишечный тракт, лимфатические узлы, дыхательную систему, у женщин – молочные железы. В отличие от солитарной, такая плазмоцитома обычно дает многочисленные метастазы, которые быстро распространяются по кровеносным сосудам и поражают лимфатическую систему.
Причины возникновения и развития плазмоцитомы
Точные причины миеломной болезни до сих пор не установлены, но специалисты утверждают: один из факторов развития недуга – генетика. В отдельных случаях причиной возникновения становились вирусы.
Сегодня ученые ведут большую работу для того, чтобы детально изучить патогенез и выяснить, что дает толчок к неконтролируемому размножению плазмоцитов.
Диагностика заболевания
Для постановки точного диагноза пациенту предстоит масштабная и тщательная диагностика. Быстрый и надежный метод при обнаружении признаков заболевания – анализы крови. Развернутое лабораторное исследование покажет, каких клеток в крови в избытке, а какие показатели – в норме. Так специалисты получат первые представления о стадии плазмоцитомы и о том, как далеко уже зашел процесс вытеснения здоровых клеток.
С помощью анализа мочи можно выявить наличие в организме моноклональных белков, или белков Бенс-Джонса.
Следующий этап диагностического обследования – пункция костного мозга. Специалисты установят, в норме ли процесс деления клеток и выявят возможное изменение хромосом.
Если плазмоцитома уже повлияла на состояние костной ткани и привела к ее уменьшению, это покажет самый распространенный метод визуальной диагностики – рентген. С помощью компьютерной томографии (КТ) можно получить еще более точные результаты, а если есть подозрения, что болезнь уже затронула костный мозг, пациенту дополнительно назначается магнитно-резонансная томография (МРТ).
Методы лечения
Какой будет терапия при плазмоцитоме, зависит от стадии заболевания. Не менее важно точно установить форму развития опухоли. При ранней диагностике и грамотно подобранном лечении есть все шансы повысить сроки выживаемости до 5 лет. Как правило, при лечении плазмоцитомы применяют следующие методы:
- Медикаментозное лечение;
- Химиотерапия и лучевая терапия;
- Хирургическое вмешательство.
Для пациентов младше 70 лет при стабильном общем состоянии организма, как правило, назначается хирургическая операция с удалением плазмоцитомы и последующей химиотерапией. По окончании курса проводится трансплантация собственных стволовых клеток крови.
Пациенты старшего возраста чаще всего проходят лечение методом стандартной химиотерапии. Локализированные опухоли в ряде случаев хорошо поддаются и лечением с помощью лучевой терапии направленного действия. Здоровые ткани при этом не затрагиваются. Хорошо показало себя и применение высокоэффективных противоопухолевых препаратов и иммуномодулирующих веществ. Их сочетание позволяет достичь высоких показателей ремиссии у пациентов – до 70 процентов.
Что же касается профилактики плазмоцитомы, то здесь рекомендации – простые и стандартные. Здоровый образ жизни, физическая активность, стабильность нервной системы значительно уменьшают риск возникновения опасного недуга.
Информация носит справочный характер и не является руководством к действию. Не занимайтесь самолечением. При первых симптомах заболевания обратитесь к врачу.
Читайте также:
